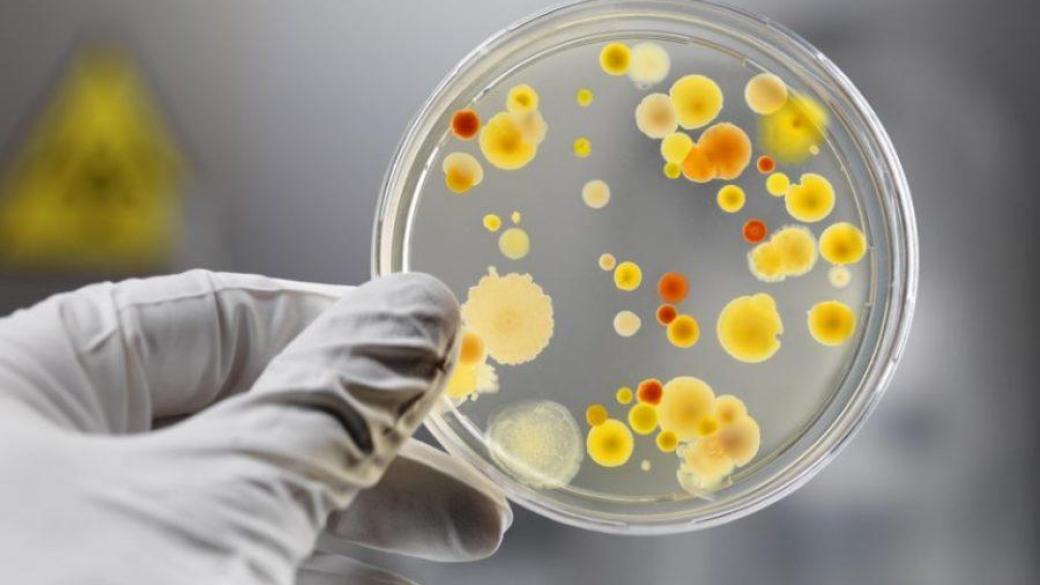

В детском саду города Збараж Тернопольской области зафиксирована вспышка сальмонеллеза, сообщает пресс-центр областного лабораторного центра Минздрава.
Специалисты уже установили источник передачи заболевания — сырые куриные яйца, зараженные сальмонеллой. Отравление детей произошло из-за нарушения технологии приготовления блюд, ненадлежащее содержание пищеблока в учреждении.
Согласно сообщению, по состоянию на утро пятницы, 6 апреля, было зарегистрировано 27 случаев заболеваний, в том числе 23 среди детей.
«Информация для реагирования направлялась в Госпотребслужбу, но ответ о принятии каких-либо мер не получен. С целью локализации и ликвидации очага сальмонеллеза продолжаются противоэпидемические мероприятия», — отметили в центре.
Новости по теме

Оккупанты вывозят детей из Токмака и Полог на Запорожье в захваченный Бердянск
Оккупанты вывозят детей из Токмака и Полог на Запорожье в захваченный Бердянск

Стало известно, куда оккупанты депортируют детей из Запорожской области
Стало известно, куда оккупанты депортируют детей из Запорожской области

В некоторых регионах Харьковщины объявили принудительную эвакуацию детей
В некоторых регионах Харьковщины объявили принудительную эвакуацию детей

В оккупированном Мариуполе зафиксирована вспышка холеры среди детей
В оккупированном Мариуполе зафиксирована вспышка холеры среди детей